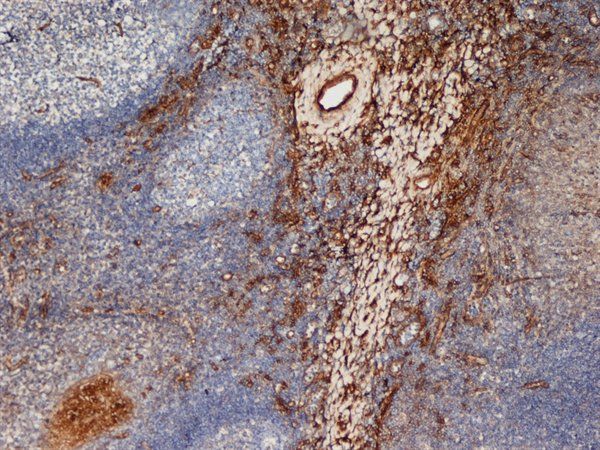
产品封面图

相关产品推荐更多 >
万千商家帮你免费找货
0 人在求购买到急需产品
- 详细信息
- 询价记录
- 文献和实验
- 技术资料
- 免疫原:
Monocyte-derived dendritic cells.
- 亚型:
IgG2a
- 形态:
Liquid
- 保存条件:
Store as concentrated solution. Centrifuge briefly prior to opening vial. For short-term storage (1-2 weeks), store at 4ºC. For long-term storage, aliquot and store at -20ºC or below. Avoid multiple freeze-thaw cycles.
- 克隆性:
Monoclonal
- 标记物:
Unconjugated
- 适应物种:
Human
- 保质期:
12 months from the shipping date of the product.
- 抗原来源:
Human
- 目录编号:
GTX42267
- 级别:
Primary Antibodies
- 库存:
Available
- 供应商:
GeneTex
- 宿主:
Mouse
- 应用范围:
IHC-Fr
- 浓度:
1.0 mg/ml (Please refer to the vial label for the specific concentration.)
- 靶点:
This antibody recognizes human CD206, otherwise known as macrophage mannose receptor (MMR).
- 抗体英文名:
Mannose Receptor antibody [7-450]
- 抗体名:
Mannose Receptor 抗体 [7-450]
- 规格:
200 μg
IHC-Fr analysis of human tonsil tissue using GTX42267 Mannose Receptor antibody [7-450].
风险提示:丁香通仅作为第三方平台,为商家信息发布提供平台空间。用户咨询产品时请注意保护个人信息及财产安全,合理判断,谨慎选购商品,商家和用户对交易行为负责。对于医疗器械类产品,请先查证核实企业经营资质和医疗器械产品注册证情况。
- 作者
- 内容
- 询问日期
文献和实验Blagojevi? V et al., Life Sci 2018 (PMID:29427649)
甘露糖受体 (mannose receptor , MR) 主要表达在M中表面,为单链跨膜分子,结构不同于前面提到的甘露糖结合凝集素,其胞外段包括两种结构:一是8个C型凝集素结构域的连续排列,负责配体的内吞转运;二是远膜端富含胱氨酸的凝集素结构域,识别硫酸化的糖类偶联物 识别PAMP的甘露糖受体和清道夫受体丸甘露糖受体结构示意图。 胞膜外8个C型凝集素结构域连续排列,负责配体的内吞转运;远膜端为富含胱氨酸的凝集素结构域。 B清道夫受体A类中I型分子三螺旋聚合
Exploiting Fc Chimaeric Proteins for the Identification of Ligands Specific for the Mannose Receptor
. In this chapter we describe our experience in the use of proteins containing selected regions of the mannose receptor fused to the Fc region of human IgG1 or murine IgG2b. Using these reagents we have discovered new and unexpected ligands for the mannose receptor
Monoclonal Antibodies to Cytochromes P450
from the clonal selection theory of Burnet and colleagues (3 ), which stated that each B-lymphocyte antibody-forming cell and its progeny is committed to the production of a single, unique type of antibody molecule. This chemically defined MAb molecule
技术资料暂无技术资料 索取技术资料